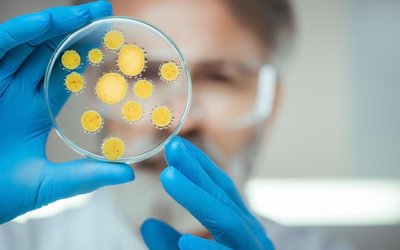
Botanix Pharmaceuticals receives FDA grant for antibacterial product BTX 1801

BOT
Director Trades
| Date | Director | Value |
|---|---|---|
| V. Ippolito | $1,672,000 |
Company News

Trump’s CBD Comments Ignite US Cannabis Stocks Surge – Will ASX Companies Follow Suit?
Shares of cannabis and CBD-related companies surged on Monday after US President Donald Trump posted on Truth Social that hemp-derived cannabidiol (CBD), especially in senior healthcare, “could revolutionize” treatment by reducing disease progression and providing an alternative to prescription drugs. He further reiterated his administration is exploring reclassifying marijuana under federal law, a change that could […]

Botanix Pharmaceuticals prepares new drug application for novel gel to treat excessive underarm sweating
Clinical dermatology company Botanix Pharmaceuticals (ASX: BOT) is preparing to submit a new drug application (NDA) for novel asset Sofpironium Bromide gel 15% for the treatment of excessive underarm sweating. The application will go to the US Food and Drug Administration before the end of the September quarter and will be followed up with preparations […]

Botanix Pharmaceuticals tracks commercial dermatology path
Botanix Pharmaceuticals (ASX: BOT) has provided the market with an update on its progress in transforming into a commercial-stage dermatology company following the acquisition of its latest asset, Sofpironium Bromide. The dermatology company had been focused on developing synthetic cannabinoid treatments for skin diseases including rosacea and acne before it announced the acquisition earlier this […]

Botanix acquires novel medical dermatology asset to treat axillary hyperhidrosis
Botanix Pharmaceuticals (ASX: BOT) has acquired novel dermatology asset Sofpironium Bromide gel 15% for the treatment of primary axillary (underarm) hyperhidrosis, a medical condition which results in excessive underarm sweating. The acquisition has been agreed with US publicly-listed company Brickell Biotech Inc which developed the gel on the back of phase 3 pivotal studies including […]
Botanix Pharmaceuticals receives FDA grant for antibacterial product BTX 1801
Amid the difficulties created by the COVID-19 pandemic, synthetic cannabinoid company Botanix Pharmaceuticals (ASX: BOT) unveiled an operational boost in the form of support from the US FDA to fast track its first antibacterial product BTX 1801. Earlier today, the company announced that the FDA’s Office of Antimicrobial Products had granted BTX 1801 – a treatment […]

Botanix Pharmaceuticals plans new study into antimicrobial platform and BTX 1801
Synthetic cannabinoid company Botanix Pharmaceuticals (ASX: BOT) has unveiled the next phase of development for its cannabinoid antimicrobial platform and lead program BTX 1801. Earlier today, Botanix declared it had achieved “significant progress” and is now commencing its first clinical research – a phase 2a study into BTX 1801, targeting the prevention of surgical site infections (SSIs). […]

Botanix’s CBD-based product destroys superbug skin infections in another ‘world first’
In another “world first” this week, Botanix Pharmaceuticals (ASX: BOT) has revealed its antimicrobial cannabidiol (CBD)-based product BTX 1801 can treat serious skin infections including superbugs. The study using BTX 1801 was carried out in collaboration with Dr Mark Blaskovich at the University of Queensland. Designed to target bacterial skin infections, BTX 1801 has been […]

Botanix study finds CBD has anti-inflammatory and immune modulating effects on skin disease
New results from a “world-first” study by Botanix Pharmaceuticals (ASX: BOT) has identified significant anti-inflammatory and immune modulating effects from using cannabidiol (CBD) to treat skin diseases such as psoriasis. The medical dermatology company today announced interim results for the phase 1b study on its BTX 1308 product, which contains a synthetic form of CBD […]

Botanix Pharmaceuticals and University of Queensland to develop cannabidiol treatment for superbugs
Medical dermatology company Botanix Pharmaceuticals (ASX: BOT) is moving ahead with developing its BTX 1801 pipeline product, a cannabidiol-based treatment for various dermatological conditions. BTX 1801 is a novel antimicrobial product with the potential to address unmet needs in serious skin infections. Development so far has been positive with Botanix reporting that this particular branch of its […]

Botanix Pharmaceuticals fully funded to complete phase 2 atopic dermatitis trial
Medical dermatology company Botanix Pharmaceuticals (ASX: BOT) has raised A$8 million through an oversubscribed placement to professional, institutional and sophisticated investors across Australia and Asia. The raising comes at a critical juncture in the company’s development as it looks to conduct a series of highly anticipated clinical trials commencing next month. Botanix said that the funds generated […]
